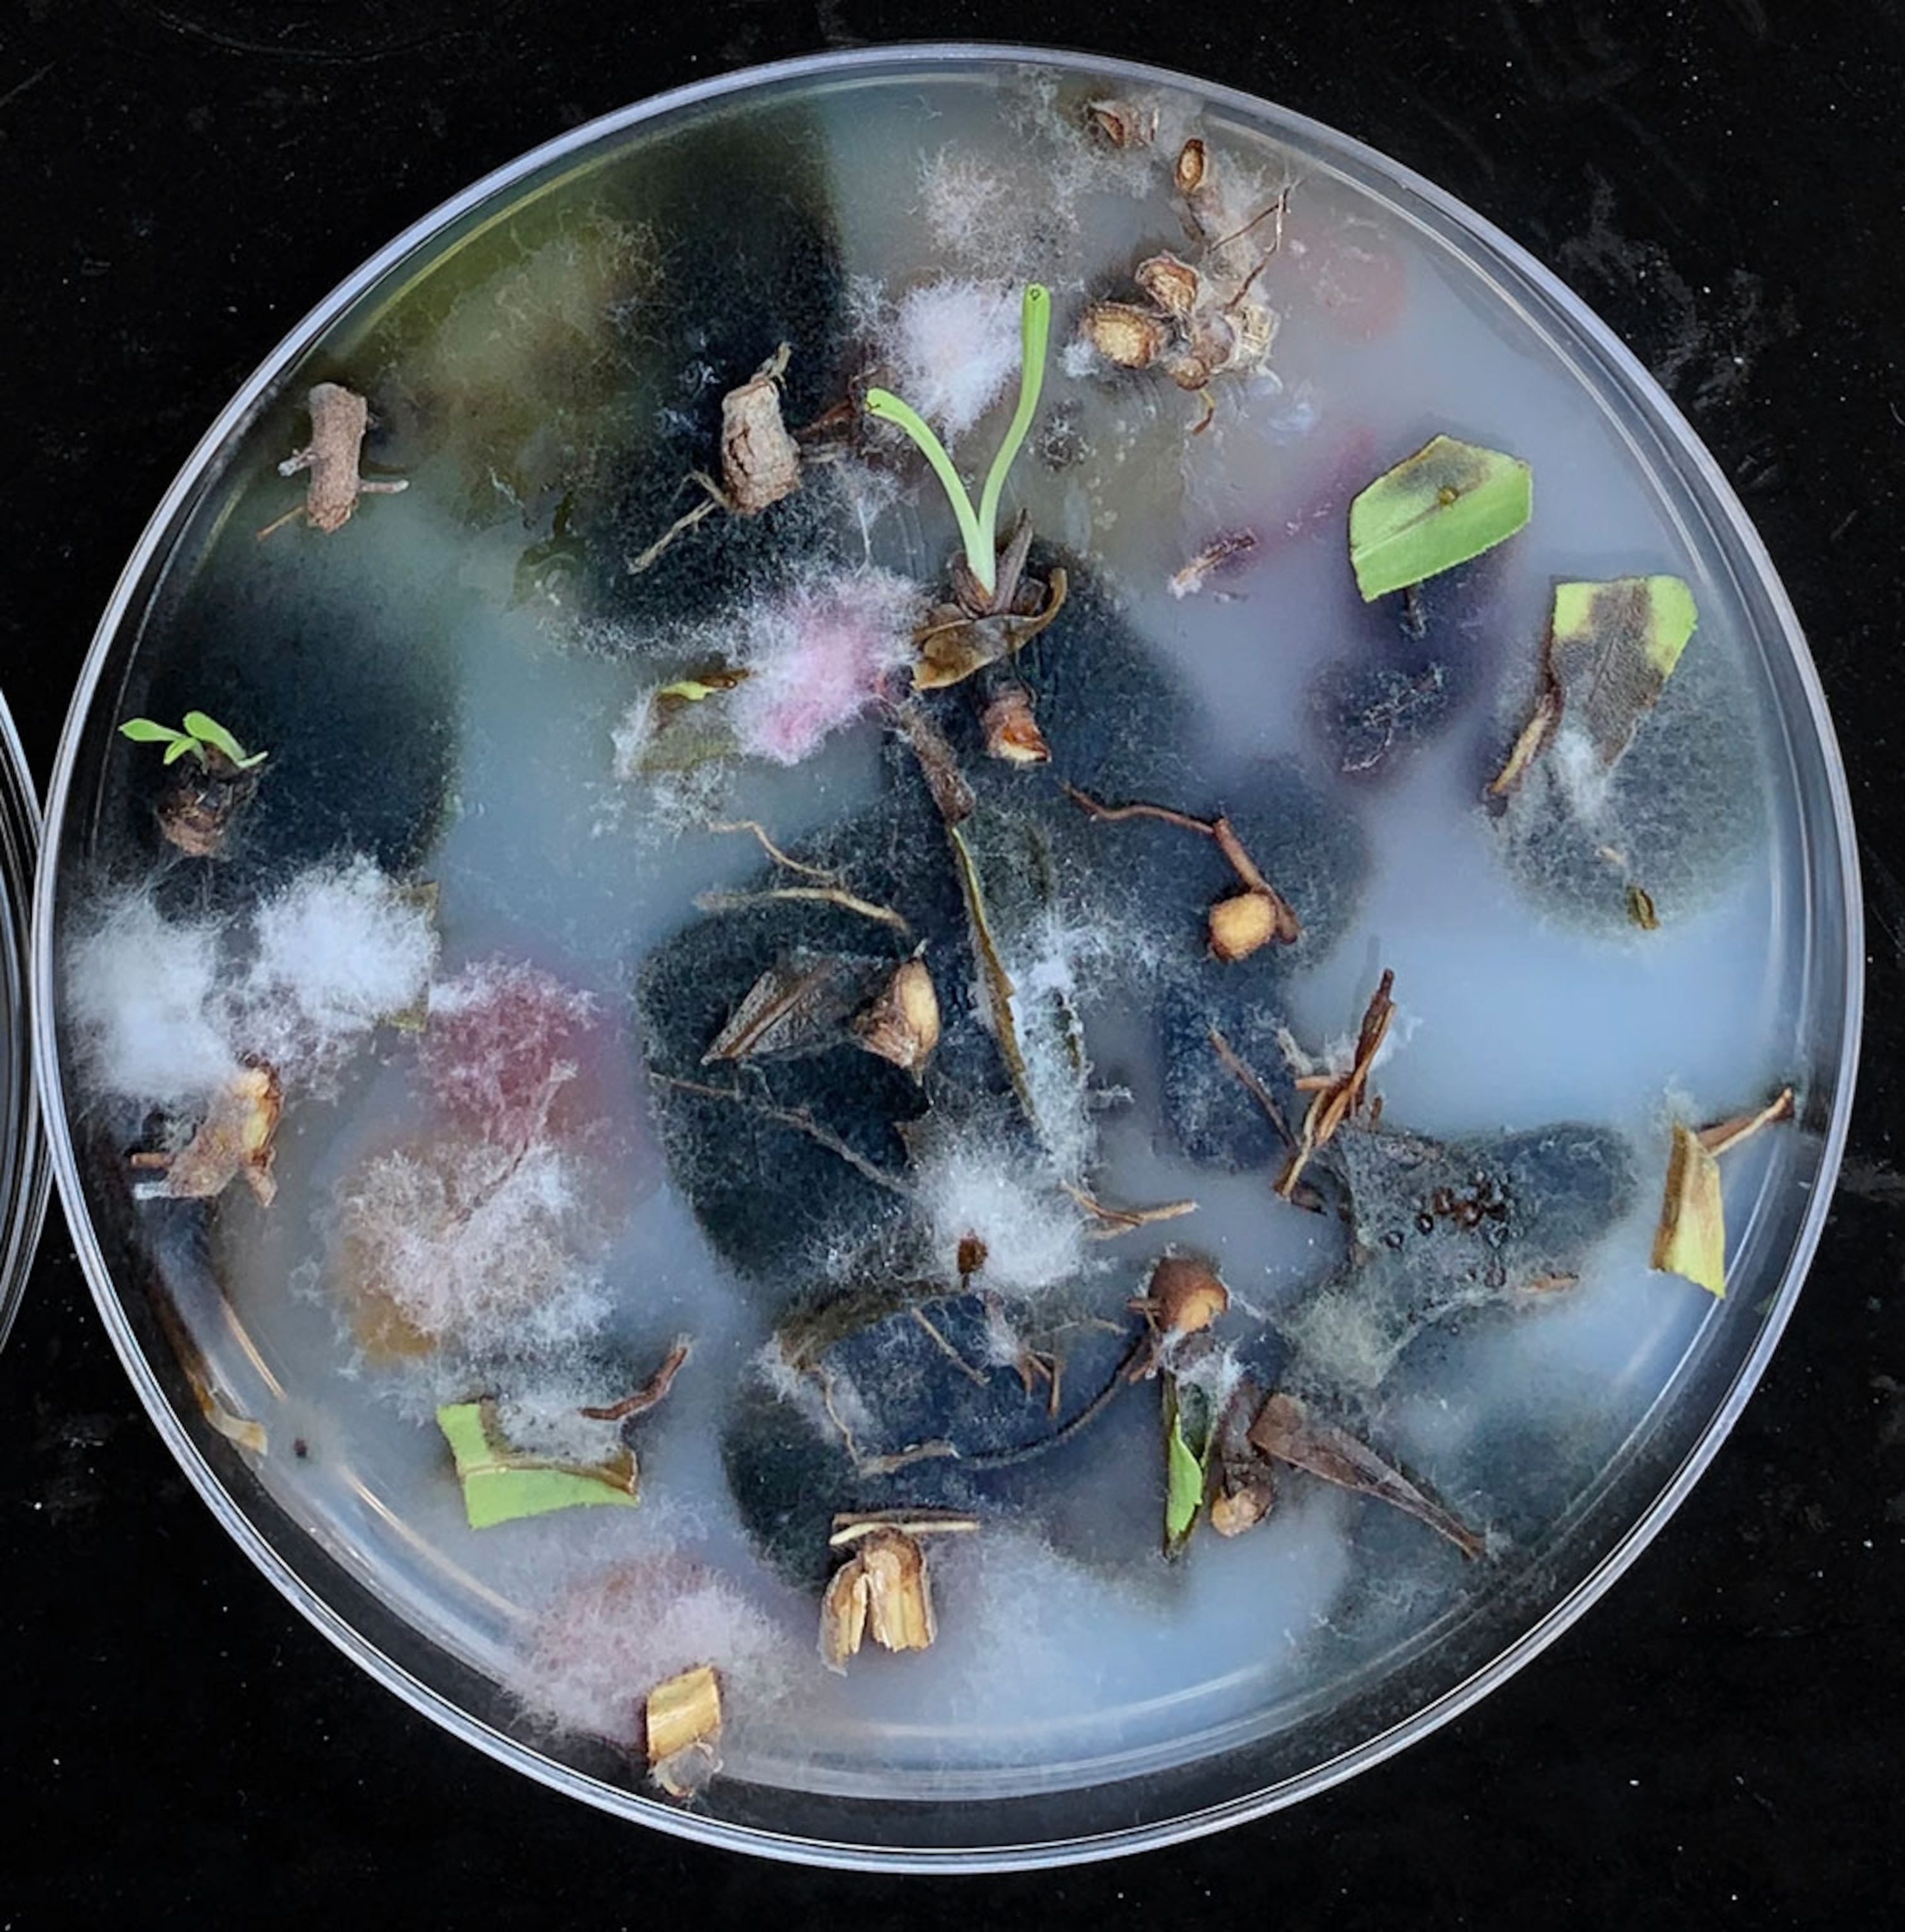

Does travel really open your mind?
By George Stone, TRAVEL Executive Editor
The idea that travel makes you a more open-minded person is rooted more in well-meaning fiction than in fact. One of the most frequently quoted justifications for seeing the world is a snippet from Mark Twain’s The Innocents Abroad: “Travel is fatal to prejudice, bigotry, and narrow-mindedness, and many of our people need it sorely on these accounts. Broad, wholesome, charitable views of men and things can not be acquired by vegetating in one little corner of the earth all one’s lifetime.”
But if travel truly were fatal to prejudice, bigotry, and narrow-mindedness, wouldn’t more of the 1.4 billion annual international tourists (pre-pandemic) have made the world kinder and less biased by now? (Pictured above: Tourists buying fruit juice in Siem Reap, Cambodia.)
We asked reporter Ruth Terry to look into the science behind the empathy that travel is said to encourage. “The coronavirus pandemic and, more recently, the global Black Lives Matter protests have forced an uncomfortable reckoning—that all the travel in the world might not be enough to engender the deep cross-cultural awareness people need now,” Terry writes. “While experts conclude that travel may not inspire enough empathy to turn tourists into social justice activists, the alternative—not traveling at all—may actually be worse.”
With pandemic restrictions still in place, missed opportunities to travel will have social, as well as economic, impacts. “Because travel produces encounters between strangers, it is likely to prompt empathetic-type imaginings, which simply wouldn’t be there without the proximity created by travel,” says Hazel Tucker in a 2016 study on empathy and travel.
Whether seeing the world actually opens travelers’ minds and makes them more empathetic is an unsettled question, but Anu Taranath, a racial equity professor at the University of Washington Seattle and a second-generation immigrant, says that travel is a step in the right direction. “It’s an invitation to think more carefully about our good intentions and where they really need to be challenged,” she explains. Her book Beyond Guilt Trips: Mindful Travel in an Unequal World is a super starting point.
The good news, according to some researchers, is that empathy can be learned. “If we are to move in the direction of a more empathic society and a more compassionate world, it is clear that working to enhance our native capacities to empathize is critical,” writes Harvard’s Helen Riess in a 2017 study. I’m hoping we can get back to travel and to learning from the world—soon!
Do you get this daily? If not, sign up here or forward this to a friend.
Your Instagram photo of the day

Dealing with the heat: Teens rest before jumping off a cliff at Playa Kenepa, on the Caribbean island of Curaçao. The island understands heat and how to cool off. Photographer Michael George says the island surprises with fields of cacti, flamingos, salt flats, “and some of the brightest blue water I’ve ever seen.”
Subscriber exclusive: Meet Curaçao’s winged celebrity, Bob the Flamingo
Travel on Instagram: Are you one of our 39 million followers? (If not, follow us now.)
Today in a minute
Devalued passport: The exclusion of most U.S. citizens from European Union countries because of COVID-19 is just the latest blow to holders of the blue passport. A survey says the U.S. is effectively tied with Mexico in the power of its passport to open travel doors overseas. The latest survey places Japan with the strongest passport, offering visa-free or visa-on-arrival access to 191 destinations around the world. Singapore is in second place (190 countries) and South Korea ties with Germany in third place (189 nations), CNN reports.
There be dragons: They’re ten feet long and weigh more than 300 pounds. They clamber in the Indonesian wilds or in zoos. Jason Bittel goes on the trail, carefully, of the carnivorous Komodo dragons, the closest thing we’ve got to the mythical beasts that haunt our dreams. “We have this phrase,” ecologist Tim Jessop tells Bittel for Nat Geo. “We consider Komodo dragons deadly, but not dangerous.”
Bumping into a grizzly: A woman was running a trail at Glacier National Park when she collided on Saturday—with a young grizzly. They both went down, and the grizzly ran away, National Parks Traveler reports. The Montana woman, who was leading two other runners, was able to walk back on the trail and was treated for minor injuries to her head and an arm. Park authorities have discouraged trail running, partly because the runners could surprise the bears.
Boom: A Denver-based startup says it is beginning test flights of a plane this fall that may be the first commercial supersonic carrier since the Concorde, CNN reports. The company says it hopes to begin service next year. The Concorde’s last flight was in 2003.
The big takeaway

Awash in castles: We’re talking about Wales, which has more castles per square mile than any other country in Europe. That includes Kidwelly Castle—featured in the opening scene of the classic comedy Monty Python and the Holy Grail. Why so many castles? They first served as strongholds for tax collection and treasure, then some morphed into stately homes, writes Raphael Kadushin for Nat Geo. Pictured above: Thomas Telford’s 1826 suspension bridge—one of the world’s first— leads into the town of Conwy, home of Conwy Castle.
Related: Your best castle and palace pictures
Overheard at Nat Geo
Not a rooftop pool: This is an image of the topic of today’s Overheard podcast episode: microbes. They hold the key to how we will feed a more populous planet. Above, an image of a coastal plant that was surface sterilized, cut up into pieces and placed on a petri plate within a medium that allows fungi to grow. What you're seeing is the emergence of mycelia of the fungal endophytes that live inside the plant.
In a few words
I had my last guava the day we left Puerto Rico. It was large and juicy, almost red in the center, and so fragrant that I didn’t want to eat it because I would lose the smell.Esmeralda Santiago, Writer, novelist, From When I Was Puerto Rican
Did a friend forward this to you?
On Wednesday, Victoria Jaggard covers the latest in science. If you’re not a subscriber, sign up here to also get Rachael Bale on animals, Whitney Johnson on photography, and Debra Adams Simmons on history.
The last glimpse

Did you get your steps in? For those of you trying to walk 10,000 steps a day, Allie Ghaman is an inspiration. The hiker and writer hit five million steps on the Appalachian Trail (pictured above, Maine’s trailside Flagstaff Lake). She stepped up to six million on the Pacific Crest Trail, and nearly seven million on the Continental Divide Trail. Who better to tell us about America’s 11 National Scenic Trails, idyllic but rugged (and with special considerations these past few months, amid the pandemic) “What draws hikers to these trails is not hard to understand,” Ghaman writes for Nat Geo. “Footsteps transform dots on a map and notes in a guidebook into real places. The swimming hole. The campfire under the full moon. The aspen grove. And once passed, those dots and notes are further transfigured into cherished memories."